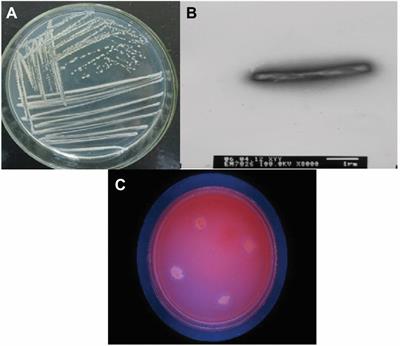

Original Research
Published on 13 Jan 2023
Effect of yeast culture supplementation in sows during late gestation and lactation on growth performance, antioxidant properties, and intestinal microorganisms of offspring weaned piglets
in Food Microbiology
- 4,688 views
- 9 citations